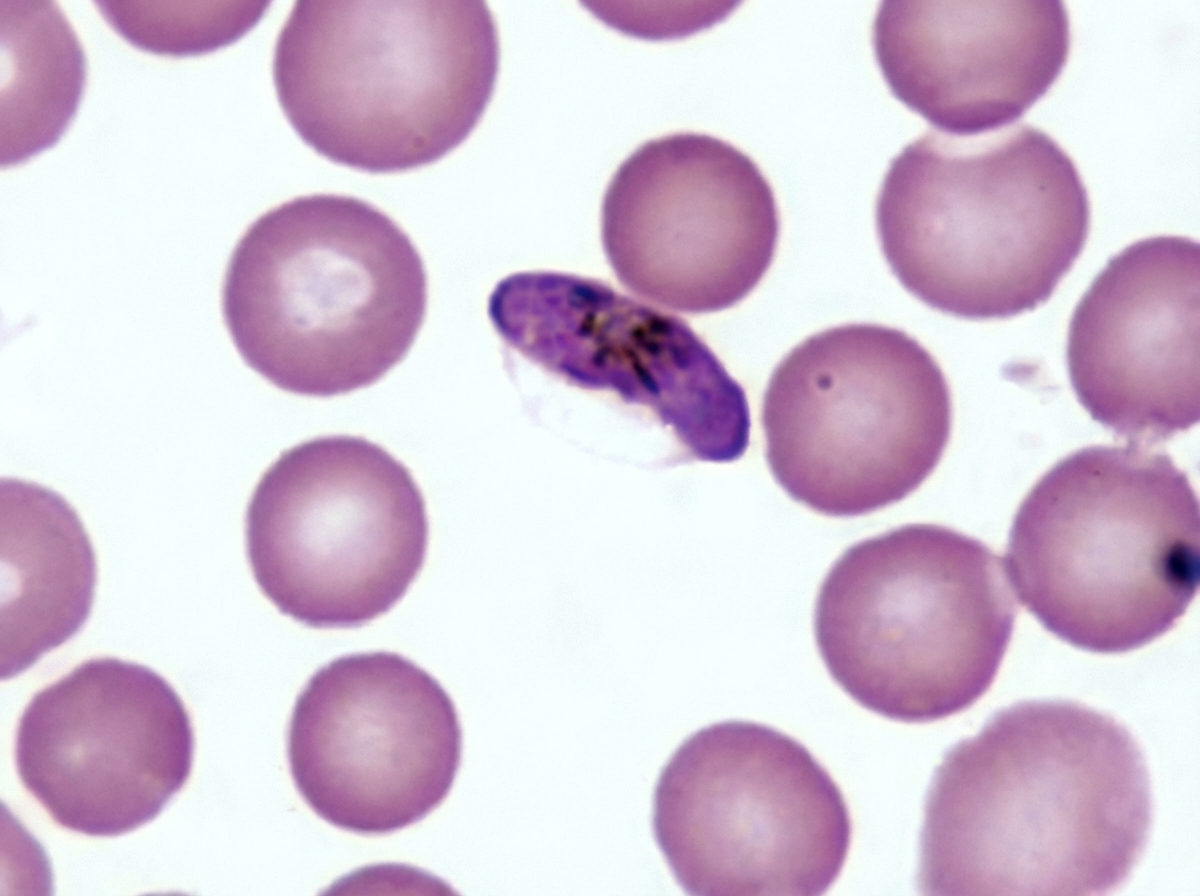
Image for question 1296

Which of the following is the classical drug for clinical cure in malaria?
A male patient with a history of MSM presents with urethral discharge. There is penicillin resistance on testing. Which drug should be given?
Patient came with fever headache and nuchal rigidity. LP shows gram-negative diplococci in gram stain. Which of the following will be used for chemoprophylaxis in close contacts of a patient with meningococcal meningitis?
A 45-year-old AIDS patient was started on anti-retroviral therapy following which he develops decrease in visual acuity. Fundus examination was done. All are used for management of the patient except?

Which of the following drugs is useful for the following condition? (Recent NEET Pattern 2016-17)

All of the following drugs will act on the following stage of malarial parasite except:
Based on the above diagnosed patient of Myasthenia Gravis, which of the following antibiotics is LEAST likely to exacerbate the condition?

Best drug for the condition shown below is: (NEET Jan 2018)

Choice of drug for management of the parasitic infection shown below is:

A 24-year-old patient presents with a 1-week history of vulvar itching and vaginal discharge. She says that she has had intercourse with two individuals in the past 6 months without the use of a condom. On physical examination, the vulva is edematous. Discharge is present on the vaginal walls and at the cervical os. Wet smear of vaginal secretions shows epithelial cells, white blood cells, and flagellate protozoa. You prescribe an antibiotic. What warning do you give about this particular treatment?
Explanation: ***Chloroquine*** - **Clinical cure** in malaria refers to the eradication of the **asexual erythrocytic forms** of the parasite, which are responsible for the clinical symptoms. - **Chloroquine** is the classical 4-aminoquinoline drug historically used as the prototype for clinical cure, acting specifically against asexual blood stages in chloroquine-sensitive *Plasmodium* species. - It remains the drug of choice for *P. vivax*, *P. malariae*, and *P. ovale* in areas without resistance. *Primaquine* - Primarily used for **radical cure** (preventing relapse) by eliminating **hypnozoites** (dormant liver stages) in *P. vivax* and *P. ovale*. - Also kills **gametocytes** (sexual stages) to reduce transmission, but does NOT provide clinical cure as it has minimal activity against asexual blood stages. *Artesunate* - A fast-acting artemisinin derivative that rapidly clears **asexual blood stages** and is used in Artemisinin-based Combination Therapy (ACT) as first-line treatment for *P. falciparum*. - While artesunate does achieve clinical cure in modern practice, chloroquine is the **classical prototype drug** traditionally associated with this concept in pharmacology teaching. *Sulfadoxine-pyrimethamine* - A **folate antagonist** combination used as alternative treatment or for Intermittent Preventive Treatment in Pregnancy (IPTp). - Widespread resistance limits its use for clinical cure, and it's not the classical drug associated with this concept.
Explanation: ***Ceftriaxone*** - **Ceftriaxone** (a third-generation cephalosporin) is the current primary treatment for uncomplicated **gonorrhea**, especially due to rising penicillin and fluoroquinolone resistance globally. - Given the patient's presentation (urethral discharge in an **MSM** patient) strongly suggesting gonorrhea, and documented **penicillin resistance**, ceftriaxone remains the drug of choice. *Amoxiclav* - **Amoxicillin/clavulanic acid** (Amoxiclav) is ineffective for the treatment of *Neisseria gonorrhoeae* due to widespread $\beta$-lactamase production and insufficient coverage against resistant strains. - It is more commonly used for community-acquired respiratory tract infections or skin infections. *Tetracycline* - **Tetracyclines** (like doxycycline) are the preferred treatment for co-occurring **Chlamydia trachomatis** infection, but are not the primary single agent for resistant gonococcal infection. - Although historically used, tetracyclines have limited efficacy against many contemporary **gonococcal strains** and are not recommended as monotherapy for resistant gonorrhea. *Vancomycin* - **Vancomycin** is a glycopeptide antibiotic primarily used for serious infections caused by **Gram-positive** bacteria, particularly **MRSA** and *Clostridium difficile*. - It has no meaningful role or efficacy in treating **Gram-negative** infections like **gonorrhea**.
Explanation: ***Rifampicin*** - **Rifampicin** is one of the preferred agents for chemoprophylaxis against meningococcal meningitis in close contacts because it effectively eliminates **Neisseria meningitidis** colonization from the nasopharynx. - The other common options for prophylaxis include **Ceftriaxone** (single IM dose, safe in pregnancy) or **Ciprofloxacin** (single oral dose). *Amoxicillin* - Amoxicillin is commonly used for **otitis media** and **sinusitis** but is ineffective for reliable elimination of nasopharyngeal colonization by **Neisseria meningitidis**. - It is not a recommended prophylactic agent for **meningococcal disease** in close contacts. *Doxycycline* - While a broad-spectrum antibiotic, **Doxycycline** is not the standard or preferred drug for routine **meningococcal prophylaxis**. - It is often used for atypical pneumonias or tick-borne diseases like **Rocky Mountain spotted fever**. *Ethambutol* - **Ethambutol** is a primary anti-mycobacterial drug, used exclusively in the treatment regimen for **Tuberculosis (TB)**. - It has no role or efficacy in the prophylaxis or treatment of **bacterial meningitis** caused by **Neisseria meningitidis**.
Explanation: ***CMV hyperimmunoglobulin*** - CMV hyperimmunoglobulin is typically used for prevention or treatment of CMV disease, particularly in transplant recipients or immunocompromised individuals, but **not as a primary treatment for established CMV retinitis**. - Its role is minimal in direct management of vision-threatening retinitis where antiviral agents are the mainstay. *Ganciclovir intraocular pellets* - **Ganciclovir intraocular pellets** are a form of localized therapy directly implanted into the eye to provide sustained release of the antiviral drug. - This method ensures high local drug concentrations, effective against **CMV retinitis**, especially in cases where systemic treatment is problematic or retinitis is severe. *Valganciclovir* - **Valganciclovir** is an oral prodrug of ganciclovir, which is commonly used as a systemic treatment for **CMV retinitis** due to its good bioavailability. - It is effective in both the induction and maintenance phases of treatment for CMV retinitis. *Foscarnet* - **Foscarnet** is an antiviral agent effective against **CMV**, particularly useful in cases of ganciclovir resistance or intolerance due to its different mechanism of action. - It is administered intravenously and is a well-established treatment option for **CMV retinitis**.
Explanation: ***Albendazole*** - The image displays a **serpiginous, erythematous track** on the foot, characteristic of **Cutaneous Larva Migrans (CLM)**, also known as creeping eruption. This condition is caused by hookworm larvae (e.g., *Ancylostoma braziliense*) that penetrate the skin from contaminated soil. - **Albendazole** is an anthelmintic agent that works by selectively binding to **beta-tubulin** of parasitic worms, inhibiting microtubule polymerization and impairing glucose uptake, leading to their starvation and death. It is the **first-line treatment for CLM** with high efficacy (typically 400 mg daily for 3-5 days). *Metronidazole* - This is an antiprotozoal and antibacterial agent effective against anaerobic bacteria and protozoa (*Giardia*, *Entamoeba*, *Trichomonas*) - **Not effective** against nematode larvae causing CLM - Works through reduction of the nitro group, disrupting DNA - a mechanism that doesn't affect helminth larvae *Doxycycline* - This is a tetracycline antibiotic used for bacterial infections - Has no anthelmintic activity against hookworm larvae - May be used for secondary bacterial infections complicating skin lesions, but not for treating the underlying parasitic cause *Praziquantel* - This is an anthelmintic agent primarily effective against **cestodes (tapeworms)** and **trematodes (flukes)** - Works by increasing cell membrane permeability to calcium ions - **Not effective** against nematode larvae (hookworms are nematodes) - Used for conditions like schistosomiasis, cysticercosis, and tapeworm infections
Explanation: ***Chloroquine*** - **Chloroquine** is a potent **blood schizonticide** that specifically targets the asexual erythrocytic stages of malaria parasites (trophozoites and schizonts) by inhibiting heme detoxification. - It has **no significant activity against gametocytes** of *P. falciparum*, the stage visible in the image. - This is why chloroquine does **not act on the stage shown** in the image, making it the correct answer to this EXCEPT question. *Primaquine* - **Primaquine** is highly effective against **gametocytes** of all malaria species, including *P. falciparum*. - While it primarily targets the **hepatic stages** (hypnozoites) of *P. vivax* and *P. ovale* to prevent relapse, it also effectively kills **gametocytes** in the blood. - It **does act on the gametocyte stage** shown in the image. *Artemisinin* - **Artemisinin** derivatives are highly effective **blood schizonticides**, rapidly clearing asexual parasitic stages from red blood cells. - They also have **significant activity against gametocytes**, including early and mature stages of *P. falciparum*. - Artemisinin compounds **do act on the gametocyte stage** depicted in the image. *Mefloquine* - **Mefloquine** is a **blood schizonticide** used for treating and preventing malaria by killing the asexual erythrocytic stages. - While its primary action is against asexual forms, it has **some activity against immature gametocytes**, though less effective against mature forms. - Still considered to have **some effect** on gametocytes, unlike chloroquine which has essentially none.
Explanation: ***Cephalosporins*** - **Cephalosporins** are generally considered safe for patients with **myasthenia gravis (MG)** as they do not significantly interfere with neuromuscular transmission. - This makes them a suitable choice when antibiotic therapy is required in these patients, unlike many other antibiotic classes that can exacerbate MG symptoms. *Macrolides* - **Macrolides** (e.g., azithromycin, clarithromycin, erythromycin) can worsen **myasthenia gravis** by impairing neuromuscular transmission. - They produce a **nondepolarizing blockade** and can lead to acute exacerbation of muscle weakness. *Quinolones* - **Quinolones** (e.g., ciprofloxacin, levofloxacin) are known to exacerbate **myasthenia gravis**. - They achieve this by **blocking acetylcholine receptors** or presynaptically reducing acetylcholine release, leading to increased muscle weakness. *Aminoglycosides* - **Aminoglycosides** (e.g., gentamicin, tobramycin) are well-known for their potential to worsen **myasthenia gravis**. - They inhibit **presynaptic acetylcholine release** and directly depress postsynaptic excitability, causing or exacerbating neuromuscular blockade.
Explanation: ***Correct: Doxycycline*** - The image shows a **tick embedded in the skin** with surrounding erythema, indicative of a **tick bite** and potential **Lyme disease** or other tick-borne infections. - **Doxycycline** is the **drug of choice** for early Lyme disease (caused by *Borrelia burgdorferi*) and many other common tick-borne illnesses like Rickettsial infections (e.g., Rocky Mountain Spotted Fever) and Anaplasmosis. *Incorrect: Ivermectin* - **Ivermectin** is primarily used to treat **parasitic worm infections** like onchocerciasis, strongyloidiasis, and scabies. - It is **not effective** against bacterial infections transmitted by ticks. *Incorrect: Sulphonamides* - **Sulphonamides** are a class of **antibiotics** effective against various bacterial infections, but they are generally **not the first-line treatment** for tick-borne diseases. - For tick-borne illnesses, **doxycycline** typically has broader and more effective coverage. *Incorrect: Penicillin* - **Penicillin** is an **antibiotic** primarily effective against a range of gram-positive and some gram-negative bacteria, and spirochetes like *Treponema pallidum*. - While it has some activity against *Borrelia burgdorferi* (Lyme disease), **doxycycline is preferred** for early-stage Lyme disease and is specifically active against other common tick-borne pathogens where penicillin is not.
Explanation: ***Triclabendazole*** - The image displays an adult **Fasciola hepatica** (liver fluke), characterized by its **leaf-like shape** and the prominent **anterior cone** terminating in an oral sucker. - **Triclabendazole** is the drug of choice for treating **fascioliasis**, as it effectively kills both immature and mature forms of Fasciola hepatica. *Albendazole* - **Albendazole** is primarily used to treat a wide range of **intestinal nematode infections** (e.g., Ascaris, hookworm, whipworm) and some **cestode infections** (e.g., neurocysticercosis, echinococcosis). - It has **limited efficacy** against trematodes like Fasciola hepatica. *Praziquantel* - **Praziquantel** is a broad-spectrum antihelminthic drug effective against most **trematodes (flukes)**, including schistosomes and other liver flukes (e.g., Clonorchis, Opisthorchis), and **cestodes (tapeworms)**. - However, it is **ineffective against Fasciola hepatica**, making it unsuitable for this specific infection. *Niclosamide* - **Niclosamide** is an oral anthelmintic primarily used to treat **tapeworm infections (cestodiasis)**, including Taenia species and Hymenolepis nana. - It is **not effective against trematodes** like Fasciola hepatica.
Explanation: ***Avoid alcohol*** - The patient's symptoms (vulvar itching, vaginal discharge, edematous vulva) and the presence of **flagellate protozoa** on a wet smear are classic for **Trichomoniasis**. The standard treatment for Trichomoniasis is **metronidazole**. - **Metronidazole** can cause a **disulfiram-like reaction** when taken with alcohol, leading to symptoms like flushing, nausea, vomiting, abdominal cramps, and headache. Patients must be warned to completely avoid alcohol during treatment and for at least 24-72 hours after the last dose. *Avoid sun overexposure* - This warning is typically given for medications that cause **photosensitivity**, such as tetracyclines (e.g., doxycycline) or some fluoroquinolones. - Metronidazole is not commonly associated with significant photosensitivity requiring this specific warning. *Avoid taking on an empty stomach* - While some medications can cause gastrointestinal upset if taken on an empty stomach (e.g., NSAIDs, certain antibiotics), metronidazole can generally be taken with or without food. - The more critical instruction for metronidazole relates to **alcohol consumption**. *Avoid taking with grapefruit juice* - Grapefruit juice can interact with certain medications by inhibiting **cytochrome P450 enzymes** (specifically CYP3A4), altering drug metabolism and increasing drug levels. - This interaction is generally not significant or routinely warned about for metronidazole.
Beta-Lactam Antibiotics
Practice Questions
Aminoglycosides
Practice Questions
Macrolides and Ketolides
Practice Questions
Tetracyclines
Practice Questions
Quinolones
Practice Questions
Sulfonamides and Trimethoprim
Practice Questions
Antimycobacterial Drugs
Practice Questions
Antifungal Agents
Practice Questions
Antiviral Drugs
Practice Questions
Antiparasitic Agents
Practice Questions
Principles of Antimicrobial Selection
Practice Questions
Antimicrobial Resistance
Practice Questions
Get full access to all questions, explanations, and performance tracking.
Start For Free